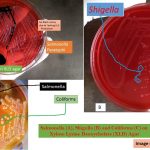
Xylose Lysine Deoxycholate (XLD) Agar is a selective, differential and indicator medium for isolation of enteric pathogens.  It also supports the growth of more fastidious enteric organisms. XLD agar was developed by Taylor. It was especially designed to allow the growth of Shigella species, and is a proven medium for the isolation of this organism. It has also been found to be an excellent medium for isolating Salmonella species as well. Salmonella and Shigella species colony characteristics on XLD agar - Salmonella Typhi: Red colonies with black centre Salmonella Paratyphi: Only red colonies no black centre Above picture is showing growth of Salmonella Typhi and Salmonella Paratyphi on XLD agar left to right respectively.

Tag: Modifications of Xylose Lysine Deoxycholate (XLD) Agar
Xylose Lysine Deoxycholate (XLD) Agar : Introduction, Principle, Preparation, Test procedure, Colony characteristics and Limitations
Introduction of Xylose Lysine Deoxycholate (XLD) Agar Xylose Lysine Deoxycholate...
Introduction of Xylose Lysine Deoxycholate (XLD) Agar Xylose Lysine Deoxycholate...
